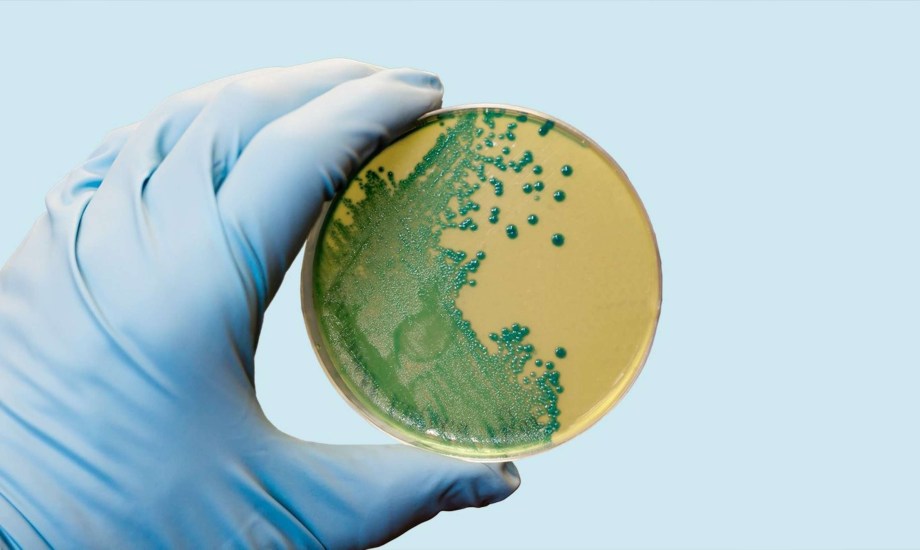
مرض الليستريا.. أسبابه وأعراضه والفئات الأكثر عرضة

العدو الصامت الذي يختبئ في طبقك.. ما هو مرض الليستيريا؟
تعتبر العدوى ببكتيريا الليستريا من المشاكل الصحية الهامة على مستوى العالم، خاصة لدى الحوامل والمسنين والأشخاص الذين يعانون من ضعف في جهاز المناعة، وعلى الرغم من أن هذه العدوى قد تبدو غير معروفة لدى الكثيرين، إلا أنها قد تؤدي إلى مضاعفات خطيرة تهدد الحياة.
في السطور التالية توضح بوابة صحة ما هو مرض الليستيريا، وتستعرض أسباب المرض، وأعراضه، وطرق انتقال العدوى، والفئات الأكثر عرضة للإصابة.
 مرض الليستريا ينتقل خلال الأطعمة الملوثة
مرض الليستريا ينتقل خلال الأطعمة الملوثة
ما هو مرض الليستيريا؟
داء الليستريات، مرض غذائي تسببه بكتيريا الليستيرية المستوحدة "Listeria "monocytogenes الموجودة في التربة، والمياه الجوفية، والنباتات المتعفنة، وبراز الحيوانات، يمكن أن يصيب الإنسان نتيجة تناول الأطعمة الملوثة، وتتراوح فترة حضانته بين يومين و3 أشهر، لكنها عادةً تستغرق من أسبوع إلى أسبوعين، حسب "Clevelandclinic".
ما هي الأطعمة التي يمكن أن تعيش فيها الليستيريا؟
تلوث الطعام هو السبب الرئيسي لعدوى الليستريا، والتي قد تتواجد في أطعمة نتناولها يومياً، مثل اللحوم، والخضراوات والفواكه الطازجة (خاصةً البطيخ)، ومنتجات الألبان غير المبسترة، ما يتطلب الانتباه جيداً والتأكد من سلامة الطعام قبل تناوله.
تعد الليستيرية المستوحدة نوعاً فريداً من البكتيريا، حيث تتمتع بالقدرة على البقاء والتكاثر في درجات الحرارة المنخفضة، ما قد يؤدي إلى مستويات خطيرة منها خلال تخزين الطعام في الثلاجات.
 من يعانون من ضعف المناعة الأكثر عرضة بمرض الليستريا
من يعانون من ضعف المناعة الأكثر عرضة بمرض الليستريا
الفئات الأكثر عرضة لمرض الليستريا
يمكن لأي شخص أن يُصاب بالمرض، لكن تعد الحوامل، وكبار السن (65 عاماً فأكثر)، ومن يعانون ضعف المناعة أو أمراضاً كالسرطان أو الإيدز، أو يتناولون أدوية مثبطة للمناعة، هم الأكثر عرضة للإصابة بالليستريا.
ما مدى شيوع الليستيريا؟
يصاب حوالي 1600 شخص بالليستيريا في الولايات المتحدة الأمريكية كل عام، لذا يُنصح بحفظ الطعام بطريقة جيدة، وشرائه من أماكن موثوقة، لتجنب الإصابة بعدوى الليستيريا البكتيرية، ولحماية أطفالك أيضاً من التلوث.